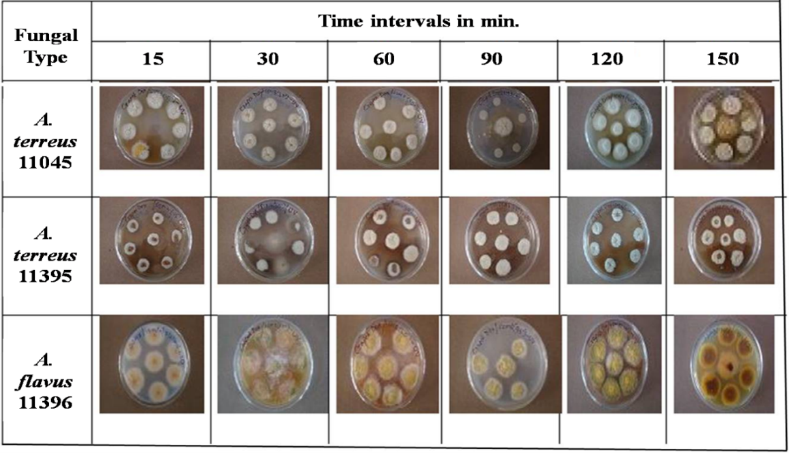

Int J Pharm Pharm Sci, Vol 8, Issue 7, 163-167Original Article
PHYSICAL MUTAGENESIS BASED STRAIN IMPROVEMENT OF ASPERGILLUS SP. FOR ENHANCED PRODUCTION OF LOVASTATIN
R. S. UPENDRAa*, PRATIMA KHANDELWALb
Dept. of Biotechnology, New Horizon College of Engineering, Outer Ring Road, Bellandur Post, Marathahalli, Bangalore 560103, Karnataka, India
Email: rsupendra.nhce@gmail.com
Received: 02 Mar 2016 Revised and Accepted: 17 May 2016
ABSTRACT
Objective: The present investigation aimed towards the strain improvement of lovastatin maximum yielding wild-type fungal strains (Aspergillus terreus-MTCC 11045, Aspergillus terreus-MTCC 11395 and Aspergillus flavus-MTCC 11396) through physical mutagenesis by applying UV random mutations.
Methods: Revival of fungal cultures on PDA plates followed by a screening of their morphological and microscopic properties. Strain improvement of screened fungi by UV (255 nm) random mutagenesis, selection of mutants based on morphological variations further submerged fermentation of selected (SmF) mutants, subsequently extraction of lovastatin from the spent broth and the extracts were analyzed for the presence of lovastatin by TLC and UV spectrophotometer scans (200-300 nm).
Results: Out of eighteen screened mutant samples seven showed positive results for the lovastatin production. Among these seven positive cultures, Aspergillus terreus 11045-90 found to yield the maximum amount of lovastatin (3912 mg/l).
Conclusion: The present study concludes by reporting the evidence of raised in the lovastatin titre by three-fold compared to the yield of the wild-type strain (996 mg/l) and confirms the achievement of strain improvement by UV random mutagenesis.
Keywords: Aspergillus terreus, Lovastatin, UV Random mutations, Strain improvement, Submerged fermentation
© 2016 The Authors. Published by Innovare Academic Sciences Pvt Ltd. This is an open access article under the CC BY license (http://creativecommons.org/licenses/by/4.0/)
INTRODUCTION
In vivo studies of the human cholesterol, biosynthetic pathway reported that the enzyme 3-hydroxy-3-methyl glutaryl coenzyme A reductase (or) HMG Co A reductase, a rate-limiting enzyme of the cholesterol biosynthesis pathway was competitively inhibited by the drug lovastatin [1]. Human and animal in vitro trails of the drug lovastatin demonstrated a strong inhibitory activity on HMG Co-A reductase (rate limiting enzyme) of the cholesterol biosynthesis pathway. The inhibitory activity of the lovastatin on HMG Co-A reductase was found to reduce the overall cholesterol levels in the human plasma [2].The HMG Co-A reductase inhibition by the lovastatin possess many beneficial health effects. Lovastatin is used along with a proper diet to help lower bad cholesterol, fats (such as LDL, triglycerides) and raise good cholesterol (HDL) in the blood. Lowering bad cholesterol, triglycerides and raising good cholesterol decreases the risk of heart disease and helps in preventing strokes and heart attacks [3]. Lovastatin was found to be effective in treatments of cancer by suppressing cellular proliferation; inducing apoptosis and necrosis in experimentally induced various cancer cell lines [4, 5]. The therapeutic application of lovastatin in hastening repair of human fractures was studied at the preclinical stage by Olivera et al., and suggested that the lovastatin administered in a nanobead preparation enhances healing of human fractures [6]. Lovastatin inhibits brain endothelial cell Rho-mediated lymphocyte migration and attenuates experimental autoimmune encephalo-myelitis [7]. Lovastatin was used in the preventive treatment of hypercholesterolemia, Parkinson’s disease, Alzheimer’s disease and atherosclerosis [8].
The filamentous fungus belongs to Aspergillus spp.,i.e. Aspergillus terreus, Aspergillus flavus and Aspergillus oryzae were the well-known producers of the drug lovastatin [9]. Lovastatin isolated from Aspergillus terreus was the first statin to be approved by FDA in 1987 for therapeutic use [10]. Various fermentation methods such as liquid surface fermentation technique [11], submerged state fermentation (SmF) technique [12, 13] and solid state fermentation techniques [14, 15] were employed for the production of lovastatin. Media optimization studies of the (SmF) process have been carried out for the enhanced production of lovastatin by many researchers [16, 17]. Many researchers were attempted to isolate lovastatin over producing natural strains. A novel rapid screening method was employed based on the bioassay of lovastatin against the yeast Candida albicans for the isolation of lovastatin over producing strains of Aspergillus terreus [18]. Lovastatin maximum producing natural strains were isolated by screening the inhibitory activity of produced lovastatin on the fungi Neurospora crassa [8]. Scanty report was documented on the strain improvement methodologies to improve the efficacy of lovastatin production by natural fungi. Lovastatin hyper producing mutants of Aspergillus terreus was developed by applying cyclic mutagenesis approach [19] and through physical (UV light) and chemical (ethyl methane sulphonate) mutagenesis methods [20].
The present investigation focuses on adaptation of strain improvement methodologies using UV random mutagenesis method on the lovastatin maximum yielding wild-type fungal strains (Aspergillus terreus-MTCC 11045, Aspergillus terreus-MTCC 11395 and Aspergillus flavus-MTCC 11396) isolated from the natural source by Upendra et al., [8] and were improved through random mutations by exposing to ultra-violet (UV) radiations at different time intervals. Initially preserved fungal cultures of Aspergillus terreus-MTCC 11045, Aspergillus terreus-MTCC 11395 and Aspergillus flavus-MTCC 11396 were revived on PDA and screened their morphological and microscopic characters. The screened fungi were exposed to UV rays at 255 nm for the different time intervals (15, 30, 60, 90, 120 and 150 min). The morphological characteristics of the VU exposed strains were compared with wild-type stains and the variable strains were selected for SmF production of lovastatin. Selected UV mutated strains were grown under SmF, followed by downstream processing to extract the secondary metabolite lovastatin. The extracts were qualitatively analyzed by TLC, UV spectrophotometer scans (200-300 nm); Seven out of the eighteen screened mutant samples were showed positive results for the lovastatin. Aspergillus terreus 11045-90 yield the maximum amount of lovastatin (3912 mg/l) followed by Aspergillus terreus 11395-90 (3441 mg/l), Aspergillus terreus 11395-120 (3057 mg/l), Aspergillus terreus 11045-120 (2680 mg/l), Aspergillus terreus 11045-150 (2378 mg/l), Aspergillus flavus 11396-90 (1916 mg/l) and Aspergillus flavus 11396-120 (1577 mg/l). The present study concludes by reporting the evidence on a rise in the lovastatin titre by three folds compare to the yield of the wild-type strain (0.996 mg/l) and confirms the achievement of improved strain by UV random mutations.
MATERIALS AND METHODS
All the chemicals and reagents used during this study were of analytical grade (Merck, India).
Screening of selected microorganism
The culture of newly identified strain [21-24]; Aspergillus terreus-MTCC 11045, Aspergillus terreus-MTCC 11395 and Aspergillus flavus-MTCC 11396 were obtained from microbial type culture collection (IMTech-Chandigarh) and host cultures were revived on the potato dextrose agar (PDA) slants and stored at 4 °C. Further, all the three revived fungal isolates were cultured on four different media i. e potato dextrose agar (PDA) medium, yeast extract mannitol agar medium (YEMA), low carbon agar medium (LCA), and czapek dox agar medium (CZA). The fully grown cultures of all the selected fungal isolates were studied morphologically (form, margin, elevation, surface, texture and color) and microscopically (hyphae type, conidia size, shape and color) using light microscopy at 100 X magnification applying fungal specific lactophenol cotton blue staining method [8].
Strain improvement by physical mutagenesis
The spores were collected from the screened strains grown on PDA slants by washing in sterile distilled water, and the spore count was carried using hemocytometer. Further, spore suspension was diluted to 1×105 spores/ml using phosphate buffer (pH-7). 4 ml of diluted spore suspension (each isolate separately) was aseptically transferred to 8 mm flat-bottom sterile petriplates and were exposed to UV radiations at 255 nm in different time intervals (15, 30, 60, 90, 120 and 150 min) with gentle shaking. The UV exposed spore suspensions of selected fungal isolates were kept to a dark for overnight to avoid photoreactivation and subsequently grown on czapek dox medium at 28 oCfor 5-7 d [20].
Screening and selection of mutants
The fully grown UV exposed cultures were screened and compared morphologically with that of wild strains, and the mutated strains were selected for the SmF process.
Submerged fermentation of mutant strains
The spores were collected from the selected mutants and were added to 50 ml of the seed culture medium (pH 6.8). The seed cultures were incubated in a rotary shaker incubator at 180 rpm at 28 °C for 24 h. Ten percent of the seed broth was inoculated to 50 ml of production medium and incubated in a rotary shaker incubator at 180 rpm at 28 °C for 10 d. Production media (composition per litre: glucose 50g, yeast extract 20g, tomato paste 30g, oat meal 20g, sodium acetate 10g, ammonium sulphate 5g, potassium dihydrogen phosphate 2g and trace element stock solution 10 ml (same as seed media) and distilled water 1 litre (pH 7.0) adjusted using 1M NaOH [8, 25].
Downstream processing of lovastatin
At the end offermentation, the broth was acidified to pH 3.0 with 10 % 1N HCl and extracted with ethyl acetate @ 1:1 ratio for two hrs maintaining standard condition (180 RPM and 70 oC temperature). By using Whatman No.40 filter paper, the fungal biomass was separated, and the filtrates were centrifuged at 3000xg for 10 min. To the collected organic phase 1% trifluoroacetic acid was added @ 1:10 ratio to facilitate the lactonization process. Then the extract was concentrated at 80 °C (without vacuum), diluted to 1 ml with acetonitrile and filtered through a 0.45-μm filter for qualitative estimation by TLC and qualitative, quantitative estimation by UV spectrometry [8].
Qualitative analysis of lovastatin by thin layer chromatography
1.5 ml of collected organic phase was, concentrated to about 50 µl using a block heater adjusted to 45 °C and applied to a pre-activated 20 X 20 cm Merck silica gel 60F254 TLC plates (Art No. 1.05554). The mobile phase used was dichloromethane and ethyl acetate (70:30, v/v). The lovastatin stock standard was prepared from the pure lactone form of the compound and dissolved in acetonitrile (3 mg/ml) which was then mixed in a test tube in equal proportion and was used as working standard. Standards and pre-concentrated samples were spotted on TLC plate and allow it to dry for 30 min and further developed three times in mobile phase. After the ¾th distance of the run the plates were observed under a hand-held UV lamp (254 nm) or stained with iodine vapor to compare the spots of both the standard and extracted samples [26].
UV spectrophotometric analysis of lovastatin
The presence of lovastatin in a prepared sample was qualitatively analyzed using UV spectrometric scan (shimadzu, model no UV-2450 and software UV-probe 2.21) between 200 nm–300 nm and subsequently estimated at 238 nm, using pure lovastatin (Biocon laboratories, Bangalore, India) as a standard [27, 28].
RESULTS
Screening of selected microorganism
Morphologic and microscopic screening of the selected fungal cultures is an important parameter to assess the growth stability and purity of the revived fungal cultures. The morphological properties of newly identified strain; Aspergillus terreus-MTCC 11045, Aspergillus terreus-MTCC 11395 and Aspergillus flavus-MTCC 11396 cultured on PDA medium was discussed at-the-table 1.
Table 1: Morphological screening of selected fungal strains cultured on PDA media
Fungal strain |
Morphological characters |
||||
Form |
Margin |
Elevation |
Surface texture |
Colour |
|
Aspergillus terreus-MTCC 11045 |
Filamentous |
Entire |
Pulvinate |
Dry and Powdery |
Light Brown |
Aspergillus terreus-MTCC 11395 |
Filamentous |
Unduled |
Pulvinate |
Dry and Powdery |
Light Brown |
Aspergillus flavus-MTCC 11396 |
Filamentous |
Entire |
Raised |
Dry and Powdery |
Light Yellow with Greenish Tinge |
The microscopic studies of the selected fungi explained that the Aspergillus terreus 11045 and Aspergillus terreus 11395 were similar with hyaline, septate hyphae and smooth, elliptical conidia forms long chains with biseriate phialides, Aspergillus flavus 11396 shows smooth, elliptical conidia form long chains biseriate phialides, extending from the upper portion of the vehicle.
The results explained that the revived cultures selected for the strain improvement methodologies were of pure in culture and steady in growth.
Screening and selection of mutants (UV random mutagenesis)
The UV exposed spore suspensions of selected fungal isolates were grown on czapek dox medium, and the fully grown mutants were selected based on their morphological variation with respect to the wild-type strains fig. 1.
Submerged fermentation and downstream processing of lovastatin
The spores of UV exposed fungal cultures were grown under submerged fermentation conditions to screen their potential for lovastatin production. At the end of 10 d of fermentation, the acidified fermentation broth was extracted for the lovastatin. Extracts of lovastatin from the SmF cultures of mutants was taken for the analysis of lovastatin.
Fig. 1: The UV exposed cultures of Aspergillus terreus-MTCC 11045, Aspergillus terreus-MTCC 11395 and Aspergillus flavus-MTCC 11396 grown on czapek dox medium
Table 2: Rf Values comparison of standard lovastatin with UV-exposed fungal SmF extracts
Wild-type strain |
UV exposure duration (in min) |
Mutant code number |
Rf value |
|
| 1. | Aspergillus terreus-MTCC 11045 |
90 |
A. terreus 11045-90 |
0.86 |
| 2. | 120 |
A. terreus 11045-120 |
0.86 |
|
| 3. | 150 |
A. terreus 11045-150 |
0.86 |
|
| 4. | Aspergillus terreus-MTCC 110395 |
90 |
A. terreus 11395-90 |
0.86 |
| 5. | 120 |
A. terreus 11395-120 |
0.86 |
|
| 6. | Aspergillus terreus-MTCC 110396 |
90 |
A. flavus 11396-90 |
0.86 |
| 7. | 120 |
A. flavus 11396-90 |
0.86 |
|
| 8. | Standard Lovastatin |
- |
- |
0.86 |
Qualitative analysis of lovastatin by thin layer chromatography
Once the run was completed, the separated solute spots were developed with iodine vapors and the results reported that among the 18 SmF extracts studied in TLC, 7 were shown spots on a TLC plate and their Rf values were found to be similar with the standard lovastatin Rf value (table 2).


Fig. 2: UV spectrophotometric analysis of lovastatin, 2A): Line graph representing the absorbance maxima (238 nm) of the positive lovastatin mutants, 2B): Bar graph representing the absorbance of the lovastatin positive mutated strains at different UV wavelengths
A. terreus 11045-90 yield the maximum amount of lovastatin (3.912 mg/l) followed by A. terreus 11395-90 (3.441 mg/l), A. terreus 11395-120 (3.057 mg/l), A. terreus 11045-120 (2.68 mg/l), A. terreus 11045-150 (2.378 mg/l), A. flavus 11396-90 (1.916 mg/l) and A. flavus 11396-120 (1.577 mg/l) in the screening work through SmF process (fig. 3).
UV spectrophotometric analysis of lovastatin
The concentration of lovastatin was calculated spectro-photometrically (in triplicates). The samples (5 ml) and the standard exhibited a peak at 238 nm in the spectrophotometer scanning (fig. 2). The results reported that among the 18 cultures screened a total of seven fungal cultures were showed positive results for lovastatin production.

Fig. 3: Bar graph of the concentration of lovastatin produced by the fungal mutants
Lovastatin standard concentrations [S1-0.2 mg/ml, S2-0.4 mg/ml, S3-0.6 mg/ml, S4-0.8 mg/ml, S5-1.0 mg/ml, S6-1.2 mg/ml], lovastatin concentration of SmF samples [A. terreus 11395-120 (3.057 mg/ml), A. terreus 11396-90 (1.916 mg/ml), A. terreus 11045-90 (3.912 mg/ml),
A. terreus 11045-150 (2.372 mg/ml), A. terreus 11045-120 (2.68 mg/ml), A. terreus 11395-90 (3.441 mg/ml), A. flavus 11396-120 (1.577 mg/ml)]. Error bars were omitted for simple presentation.
DISCUSSION
In the present study, attempts were made to improve the lovastatin maximum yielding wild-type fungi to enhance the yield of lovastatin further. Initially, all the three preserved fungal cultures were revived, and their morphological and microscopic characters were screened. The screened fungi were exposed to UV rays at 255 nm for the different time intervals (15, 30, 60, 90, 120 and 150 min) with gentle shaking. The mutants were selected based on morphological variations and were grown under SmF, followed by downstream processing to extract the metabolite lovastatin. The extracts were qualitatively analyzed by TLC, UV spectrophotometer scan (200-300 nm); 7 out of the 18 screened mutants samples were showed positive results for the productions of lovastatin. Aspergillus terreus 11045-90 yield the maximum amount of lovastatin (3912 mg/l) followed by Aspergillus terreus 11395-90 (3441 mg/l), Aspergillus terreus 11395-120 (3057 mg/l), Aspergillus terreus 11045-120 (2680 mg/l), Aspergillus terreus 11045-150 (2378 mg/l), Aspergillus flavus 11396-90 (1916 mg/l) and Aspergillus flavus 11396-120 (1577 mg/l). The yield reported by the mutant strain developed in the present study Aspergillus terreus 11045-90 (3912 mg/l) was 4 fold higher than the wild-type strain lovastatin yield (996 mg/l) [8].
A novel rapid screening method was demonstrated for isolation of lovastatin over producing stains of Aspergillus terreus. The screening methodology was based on the activity of lovastatin against the yeast Candida albicans. The study showed that the new 6-h assay had a linear correlation between the quantity of lovastatin generated by A. terreus isolates and the inhibition zone obtained on plates of C. albicans [18]. The lovastatin yield reported in this study is very less compare to the enhanced yield of the present study (3912 mg/l). 134 fungal cultures were isolated from different soil samples and were screened for lovastatin production. The maximum lovastatin-producing strain (A. terreus strain GD13-190 mg/l) among the screened was selected and subjected to rational mutation-selection program based on the resistance to lovastatin and fatty acid synthase (FAS) inhibitors, viz., iodoacetamide and N-ethyl-maleimide. The study reported that a hyper-producing mutant (EM19) exhibiting 7.5-fold (1424 mg/l) higher levels of lovastatin, which was approximately 3 fold lesser than the lovastatin yield reported in the present study [19]. A strain improvement study of A. terreus was carried out by physical and chemical mutagenesis for increased lovastatin production. Four mutant clones were obtained after physical mutagenesis, out of which two mutants were derived from UV irradiation and other two mutants from ethyl methyl sulfonate treatment. The yield of lovastatin varied from mutants to mutants and the mutant strain JPM3-UV1 produced the maximum lovastatin (1553 mg/ml), which was approximately 3 fold lesser than the lovastatin yield reported in the present study [20]. A soil fungal isolate Aspergillus terreus MTCC10831 was subjected to UV light followed by ethyl methyl sulfonate treatment for enhanced production of lovastatin. The best UV mutant SPUV002 exhibited lovastatin productivity of 32.78% higher than wild strain. The ethyl methyl sulfonates mutant SPEM142 had a yield of 663μg/ml of lovastatin. The result indicated that UV and ethyl methyl sulfonate were effective mutagenic agents for strain improvement of A. terreus MTCC10831 for enhanced production of lovastatin. The present study reported approximately 5 fold higher lovastatin yield compared to the yield of discussed study [29].
CONCLUSION
Considering these references as discussed above, it could be concluded that Aspergillus terreus MTCC 11045-90, the improved fungal isolate was found to produce highest yield (3912 mg/l) of lovastatin. It can also be seen that the present investigation led to explore the physical mutagenesis (UV random mutation) technique for improving the lovastatin yielding efficiencies of wild-type fungal isolation.
ACKNOWLEDGEMENT
We wish to express our gratitude to management and principal, New Horizon College of Engineering, Bangalore for providing us with all the facilities to undertake this research work.
CONFLICT OF INTERESTS
Declared none
REFERENCES
- Alberts AW, Chen J, Kuron G, Hunt V, Huff J, Hoffman C, et al. Mevinolin: a highly potent competitive inhibitor of hydroxymethyl glutaryl coenzyme A reductase and cholesterol lowering agent. Proc NAS U S A 1980;77:3957–61.
- Kaneko I, Hazame, Shimada Y, Endo A. Inhibitory effects on lipid metabolism in cultured cells of ML-236B, a potent inhibitor of 3-hydroxy-3-methylglutaryl-coenzyme a reductase. Eur J Biochem 1978;87:317-21.
- http://www.webmd.com/drugs/2/drug-11594-92/lovastatin-oral/lovastatin-oral/details. [Last accessed on 10 Feb 2016].
- Klawitter J, Touraj Shokati, Vanessa Moll, Uwe Christians, Jost Klawitter. Effects of lovastatin on breast cancer cells: a proteo-metabonomic study. Breast Cancer Res 2010;12:R16.
- Camelia Stancu, Floarea Serbancea, Gabriela Botez, Anca Sima. The hypocholesterolemic effect of probiotics in the hyperlipidemic hamster. Proc Rom Acad Ser B: Chem Life Sci Geosci 2008;3:145–14.
- Olivera Stojadinovic, Elizabeth Lebrun, Irena Pastar, Robert Kirsner, Stephen C Davis, Marjana Tomic-Canic. Statins as potential therapeutic agents for healing disorders. Expert Rev Dermatol 2010;5:689-98.
- Greenwood J, Walters CE, Pryce G, Kanuga N, Beraud E, Baker D, et al. Lovastatin inhibits brain endothelial cell Rho-mediated lymphocyte migration and attenuates experimental autoimmune encephalomyelitis. FASEB J 2003;17:905-7.
- Upendra RS, Pratima Khandelwal, Amiri ZR, Swetha L, Mohammed Ausim S. Screening and molecular characterization of natural fungal isolate producing lovastatin. J Microb Biochem Technol 2013;5:25-30.
- Upendra RS, Pratima Khandelwal, ZR Amiri, Aparna S, Archana C, Ashwathi M. Isolation and Characterization of lovastatin producing grade food fungi from oriental foods. World J Pharm Res 2014;3:1404-14.
- Devi Sree K, Venkateswara Rao J, Lakshmi Narasu M, SaiKrishna K. Isolation and screening of lovastatin-producing Aspergillus terreus fungal strains from soil samples. Int J Pharmacol Ther 2011;3:2772-82.
- Gabriela B, Valter V, Adela V, Jana G. A method of fermentation preparation of lovastatin by an Aspergillus terreus strain and the strain for performing the method. Patent; 1999.
- L´opez Casas JL, JA S´anchez P´erez, JM Fern´andez Sevilla, EM Rodr´ıguez Porcel, Y Chisti. Pellet morphology, culture rheology and lovastatin production in cultures of Aspergillus terreus. J Biotechnol 2004;116:61–77.
- Upendra RS, Pratima Khandelwal, ZR Amiri,Baboo M Nair. The invited session key lecture on “Optimization of a process for producing lovastatin from novel fungal isolates”.Proc SUTPBM; 2014. p. 28-34.
- Jaivel N, P Marimuthu. Optimization of lovastatin production in solid state fermentation (SSF) by Aspergillus terreus.Int J Eng Sci Res Technol 2010;2:2730-3.
- Pratima Khandelwal, Upendra RS, Vivek R, Nandhini NJ. Optimization of parameters for lovastatin production using a high yielding strain of GRAS fungi, and development of novel (geriatric) foods for its delivery as a means of cognitive and preventive health care. Proc Food Processing Technologies-Challenges & Solution for Sustainable Food Security; 2013. p. 197.
- Atalla MM, Hamed ER, El-Shami AR. Optimization of a culture medium for increased mevinolin production of Aspergillus terreus strain.Malays J Microbiol 2008;4:6-10.
- Osman ME, OH Khattab, GM Zaghlol, Rehab M, Abd El-Hameed. Optimization of some physical and chemical factors for lovastatin productivity by a local strain of Aspergillus terreus. Afr J Basic Appl Sci 2011;5:718-32.
- Vilches Ferron MA, JL Casas Lopez, JA Sanchez Perez, JM Fernandez Sevilla, Y Chisti. Rapid screening of Aspergillus terreus mutants for over production of lovastatin. World J Microbiol Biotechnol 2005;21:123–5.
- Harleen Kaur, Amarjeetkaur, HS Saini, BS Chadha. Screening and selection of lovastatin hyper-producing mutants of A. terreus using cyclic mutagenesis. Acta Microbiol Immunol Hung 2009;56:167–78.
- Jaivel N, P Marimuthu. Strain improvement of Aspergillus terreus for increased lovastatin production. Int J Eng Sci Res Technol 2010;2:2612-5.
- Upendra RS, Pratima K, Swetha, Manaswini. Molecular characterizations of the lovastatin-producing fungal isolate. Organism-Aspergillus terreus SSM4. Gen Bank; 2013.
- Upendra RS, Pratima K. Isolation and molecular characterization of natural fungal isolates producing lovastatin. Organism-Aspergillus terreus SSM3. Gen Bank; 2013.
- Upendra RS, Pratima K. Molecular characterizations of the lovastatin-producing fungal isolate. Organism-Aspergillus flavus SSM8. Gen Bank;2013.
- Upendra RS, Pratima K, Ausim M. Molecular characterization of lovastatin-producing fungal isolates. Organism-Rhizopus oryzae SSM9. Gen Bank;2013.
- Siamak, M Samiee, Nasrin Moazami, Saeid Haghighi, Farzaneh Aziz Mohseni, Saeid Mirdamadi, et al. Screening of lovastatin production by filamentous fungi. Iran Biomed J 2003;7:29-33.
- Hajko P, A Wildman. Process for the purification of HMG-CoA reductase inhibitors. U. S. Patent; 1993.
- Upendra RS, Khandelwal P. Mohammed ausim: a novel approach for enhancement of Lovastatin production using Aspergillus species. Proc SUPBT; 2012. p. 135-40.
- Upendra RS, Khandelwal P, Mohammed Ausim. A novel approach for enhancement of Lovastatin production using Aspergillus species. Int J Agric Environ Biotechnol 2013;6:779-86.
- Sreedevi K, Venkateswara Rao J, Lakshmi Narasu, Fareedullah Md. Strain improvement of Aspergillus terreus for the enhanced production of lovastatin, an HMG-COA reductase inhibitor. J Microbiol Biotechnol Res 2011;1:96-100.